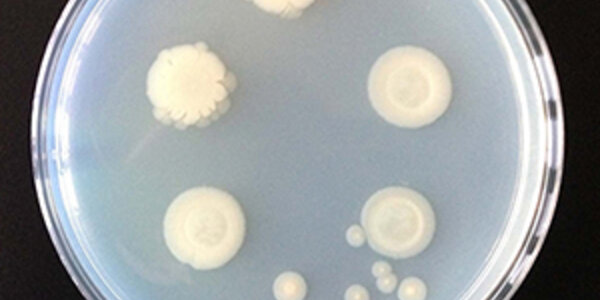
Article teaser image

Open Gut Swimming: Fish Skin Immune Responses Resemble Those Of Stomach
A new study has found that not only does fish skin resemble the gut morphologically, but key components of skin immune responses are also akin to those of the gut.
Fish skin is unique in that it lacks keratin, the fibrous protein found in mammalian skin that provides a barrier against the environment. Instead, the epithelial cells of fish skin are in direct contact with the immediate environment: water. Similarly, the epithelial cells that line the gastrointestinal tract are also in direct contact with their immediate milieu.
The results not only are of interest on the level of…